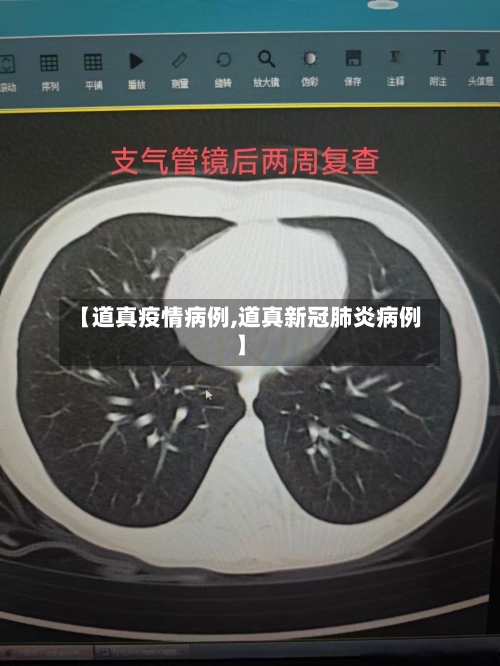
【道真疫情病例,道真新冠肺炎病例】

班级开学第一课疫情防控教案大全
开学第一课疫情防控班级教案1 活动目标 『1』能从绘本中获取关于新型冠状病毒的信息。 『2』可以用自己的语言表达出冠状病毒的有关内容 。 『3』了解预防病毒的防护 措施 有哪些。

“当当当,口罩小卫士登场了!我就是保护人类的口罩小卫士!我能把病毒挡在外面~我能撑起小伞 ,为你的鼻子遮风挡雨;我能拉起防护网,为你的嘴巴拦住病毒。
幼儿园开学第一课疫情防控教案1 活动目标 了解有关幼儿容易传染上的传染病的情况,根据自己的生活经验说出预防疾病的方法 。 培养幼儿的语言表达能力。 幼儿学习一些基本的预防传染病的方法 ,增强幼儿预防疾病的意识。
开学第一课幼儿园疫情教案1 班会主题 抗击新冠肺炎,我们共同努力 班会背景 由于突发的疫情,使得过年期间正应该是走亲访友 ,与朋友们玩耍的机会没有了,学生被要求进行自我保护,不能与外人进行接触,长时间的封闭生活使得学生出现了浮躁 、懒散、害怕、焦虑的情况 ,影响身体健康 。

学校出现流感疫情该如何应对
〖壹〗 、学校出现流感疫情时,需通过加强健康监测、落实隔离措施、强化清洁消毒 、合理安排教学等系统性防控手段应对,同时关注师生心理健康 ,最大限度降低疫情传播风险。 具体措施如下:加强健康监测与病例管理 严格晨午检制度:每天对学生和教职工进行体温检测及症状筛查,重点关注发热、咳嗽、流涕等流感样症状。
〖贰〗、学校出现流感疫情时,应通过加强健康监测 、严格隔离管理、全面清洁消毒、合理安排教学及强化防护宣传等措施进行综合应对 ,具体如下:加强健康监测与筛查 落实每天晨检 、午检制度,重点检查学生及教职工是否出现发热、咳嗽、流涕等流感症状。
〖叁〗 、避免交叉感染 隔离与就医:若学生出现发热症状,需立即采取防护措施(如佩戴口罩) ,并尽快就医 。确诊流感后,学生应居家隔离或住院治疗,避免返校直至症状消失且体温恢复正常48小时以上。物品消毒:对确诊学生使用过的物品(如文具、餐具、衣物等)进行彻底消毒 ,可使用含氯消毒剂或75%酒精擦拭。
学校流感暴发疫情停课标准
班级停课标准满足以下任一条件时,班级需停课:病例数量阈值:当天新发现流感样病例达5例及以上;或7天内同一班级流感样病例累计达到15例及以上 。病例比例阈值:班级现症流感样病例达30%及以上。重症病例阈值:一周内发生2例及以上实验室确诊流感住院或死亡病例(不包括门诊留观病例)。停课时长:通常停课4天,期间需持续监测疫情发展 。
班级停课标准当天新发现流感样病例5例及以上:流感样病例定义为发热(腋下体温超过38度),伴咳嗽或咽痛之一者。当班级在当天新发现达到这一症状标准的病例达到5例及以上时 ,可切换线上教学。
具体停课标准停课需满足以下条件之一:班级内当天新发现流感样病例达5例及以上:例如某班级一天内新增5名学生出现发热(体温≥38℃) 、咳嗽、咽痛等流感样症状,即可触发停课评估 。班级现症流感样病例达30%及以上:若某班级共有40名学生,其中12名及以上同时出现流感样症状 ,也需启动评估。
疫情ab班是什么意思
〖壹〗、疫情AB班的意思 疫情AB班,即A班级授课老师的声音 、板书,可实时同步传递到B班级 ,契合下的教学要求。将学校各个年级教室按班级均分成A、B两个班,每个班级25人左右,固定班级、固定座位 ,确保一人一桌 。教师轮流在A、B班授课,通过实时转播,确保A 、B两个班级由原班教师同时授课 ,学生就可以享受均等的教师资源。
〖贰〗、AB岗工作制度是指在工作日内,当A岗人员因故不在岗时,由B岗人员顶岗,及时办理可以即时办理的一般性事务和紧急公务的工作制度。就是在每个窗口、每个岗位 ,都设置两名工作人员,其中工作人员A(即A角)为业务主办人员,对工作负主要责任 ,工作人员B(即B角)为协办人员,对工作负次要责任。
〖叁〗 、AB班制就是对某个岗位设置两名工作人员即A角和B角 。A角属于主办人员,对某项工作主要负责 ,B角是协办人员,对某项工作负次要责任。B角应主动熟悉并协助做好该项工作,当A角出差或其他原因不能承担完成该项工作时 ,由B角接替完成该项工作,并切实负起责任。
〖肆〗、疫情ab类区的意思是涉及风险所划分标准 。疫情防控A类指的是确诊病例和无症状感染者的密切接触者通常称为密切接触者。B类指的是确诊病例和无症状感染者的密接人员通常称为次密切接触者。
〖伍〗、监狱疫情爆发主要与民警休假制度 、疫情初期认知不足、人员接触管理不当以及信息隐瞒等因素有关,具体如下:民警休假制度与人员轮换:监狱民警实行AB班轮休制度 ,各休7天,以年初三为分界点 。年初三之前A班休息,期间可能因走亲访友、聚会等活动感染病毒。
〖陆〗 、月初,部门同事开始因小区有疑似病例而居家隔离 ,其他同事仍正常上班,但都戴上了口罩。那时外卖、火锅、炸鸡 、烧烤等生活服务还正常,大家下班后会一起聚餐 ,午间也会去公司附近商场吃饭,疫情似乎还很遥远 。3月15号左右,业内部分公司开始实行线上办公和AB班制 ,当时觉得在家办公很舒适。
深圳龙岗疾控有哪些具体的流感防控措施?
〖壹〗、深圳龙岗疾控具体的流感防控措施如下:疫情监测与报告 及时发现校园疫情:校(园)医需在日常工作中加强晨午(晚)检及因病缺勤缺课登记管理。若发现学生或教职工出现发热、咳嗽、咽痛等症状,应立即嘱咐其就医或居家隔离观察,避免疫情扩散 。
〖贰〗 、时10分左右 ,驾车离开平湖前往文锦渡口岸。防控措施:疾控部门联合公安部门初步排查后,确认密切接触者11名、密切接触者的密切接触者41名,上述52名重点人员已全部被集中隔离 ,核酸检测结果均为阴性。
〖叁〗、01 打疫苗,最重要 02 戴口罩,要牢记 03 勤洗手,不可少 04 常通风 ,空气好 05 一米线,要保持 06 不聚集,少扎堆 07 打喷嚏 ,讲礼仪 08 有症状,早就医 09 被流调,需配合 关注疫情防控消息动态 ,提高辨别能力,不造谣 、不信谣、不传谣,共同营造科学防治、理性应对的社会氛围。
〖肆〗 、强化交通站场防控机场、公路、铁路 、港口码头等交通站场需严格落实体温测量、亮码、戴口罩等措施 ,严禁红黄码人员通行,避免人员聚集 。市内公共交通 、出租车、网约车需落实戴口罩、通风消毒等措施。
〖伍〗、有重点区域旅居史的人员,必须提供三天内的核酸阴性证明方可接种。除上述接种点外 ,深圳龙岗区还可能存在其他新冠疫苗第三针接种点,可通过以下途径获取更多信息:深圳疾控平台:满足接种条件的人员可以在深圳疾控上预约接种,该平台可能会更新龙岗区最新的接种点信息 。
“甲流”高发,多所学校停课
〖壹〗 、当前甲流处于高发期,多地学校因甲流出现停课情况。以下是详细信息:疫情数据与趋势根据北京疾控中心2月22日发布的疫情周报 ,2月13日-2月19日期间,流行性感冒病例数超过新冠病毒感染病例,成为报告病例数比较多的传染病。
〖贰〗、近期多所学校因学生发烧停课 ,主要因甲型流感引发,春季是传染病高发期,需加强防范 。多地学校因甲流停课情况上海青浦:某小学班级因多名学生发热停课4天 ,经证实为甲流感染,非新冠。天津北辰:华辰学校个别班级因学生发烧暂停线下教学2天,核酸检测均为阴性 ,确诊为甲型流感。
〖叁〗、此次甲流并非特别凶猛,近来处于常规散发状态且已回落,不必过度恐慌 。具体分析如下:甲流暴发情况 多地学校停课:2月以来 ,北京 、天津、上海、浙江等地多所学校因学生感染甲型流感停课。
〖肆〗 、近期甲流高发导致学生停课现象增多,是多种因素共同作用的结果,不能简单视为常态化,但需理性看待其必要性。以下从多个角度分析这一现象:甲流高发与传播特点传播性强:甲流作为急性呼吸道传染病 ,通过飞沫、接触传播,在人群密集的校园环境中极易扩散 。